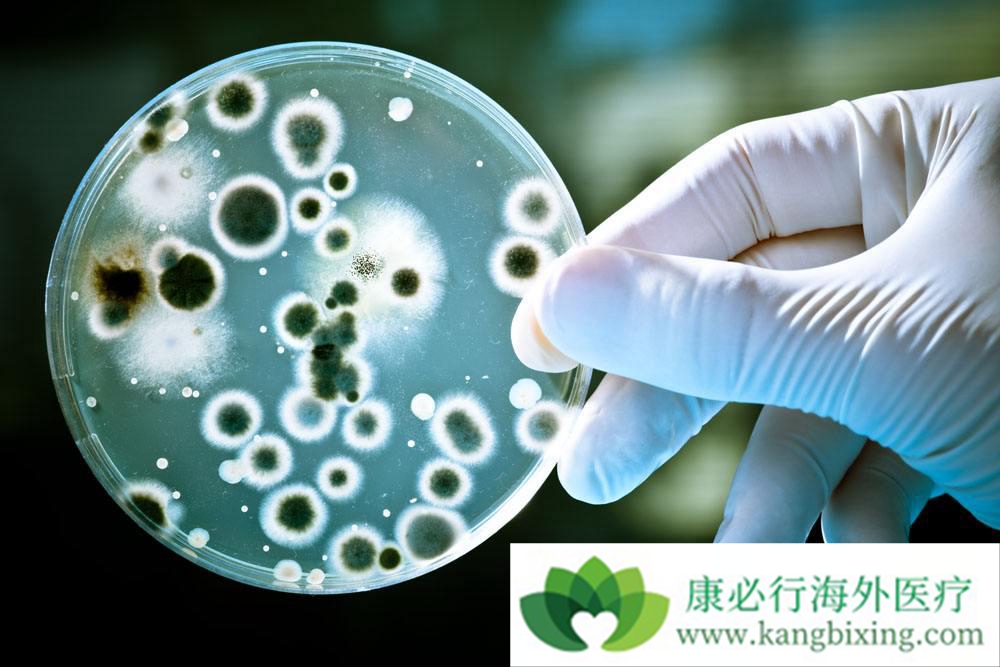
海外医疗 海外医疗

丙肝是最为可怕的感染性疾病之一,全球有近2亿的人群身上带有丙肝病毒,但是丙肝病毒极为狡猾,一开始感染丙肝并没有什么特别的症状,很多人至始至终可能都不知道自己患有丙肝病毒。海外医疗研究人员发现丙肝病毒通过分解免疫细胞之间的通信,不仅可以使免疫系统不可见,还可以建立快速进入批量生产的秘密病毒“工厂”。
丙肝从感染到疾病需要一到三个月的时间,在最坏的情况下,可能导致肝衰竭和死亡。经过研究,挪威科技大学(NTNU)的研究人员现在可以描述该疾病游击战术的重要组成部分:丙型肝炎如何将无辜的细胞转化为直接的病毒工厂。直到最近,研究人员无法在实验室中维持丙型肝炎病毒存活,因此对肝脏中病毒的复制策略知之甚少。 2006年在肝细胞中发现HCV的发现是一个里程碑。研究人员发现,丙型肝炎病毒实际上破坏了免疫系统中重要的蛋白质,以促进其自身的生长。直接操纵宿主细胞的能力是一些病毒对我们非常有害的原因。我们的细胞具有复杂的内部结构,分为不同的区域,由脂肪膜形成的不同“囊”。长期以来,已知与HCV(正极化单链RNA)具有相同遗传物质的病毒引起这些膜囊的重大变化。
海外医疗研究人员对蛋白质IRGM感兴趣,已被证明与结核分枝杆菌,麻疹病毒和艾滋病毒相关的膜变化类似。为了研究IRGM蛋白是否引起变化,他们采用CRISPR-Cas系统,这种技术越来越多地用于调节细胞,在这种情况下可以关闭肝细胞中的IRGM蛋白。当IRGM从肝细胞中除去时,病毒不能生长。其原因是丙型肝炎病毒使用一些称为高尔基体的细胞,其中蛋白质IRGM具有重要的功能。高尔基设备是一种运输中心 - 类似于邮局 - 在单元格中。它将蛋白质包装到小囊(囊泡)中,并将它们发送到需要在细胞内进入的位置,或者发送到其他细胞。丙型肝炎病毒利用这种方式建立病毒工厂,接管“邮局”,并将这些囊泡与必要的建筑物重定向到工厂正在建造的地点。这些囊泡富含脂质,病毒完全依赖于锚定其工厂建设。

添加康必行顾问,想问就问












